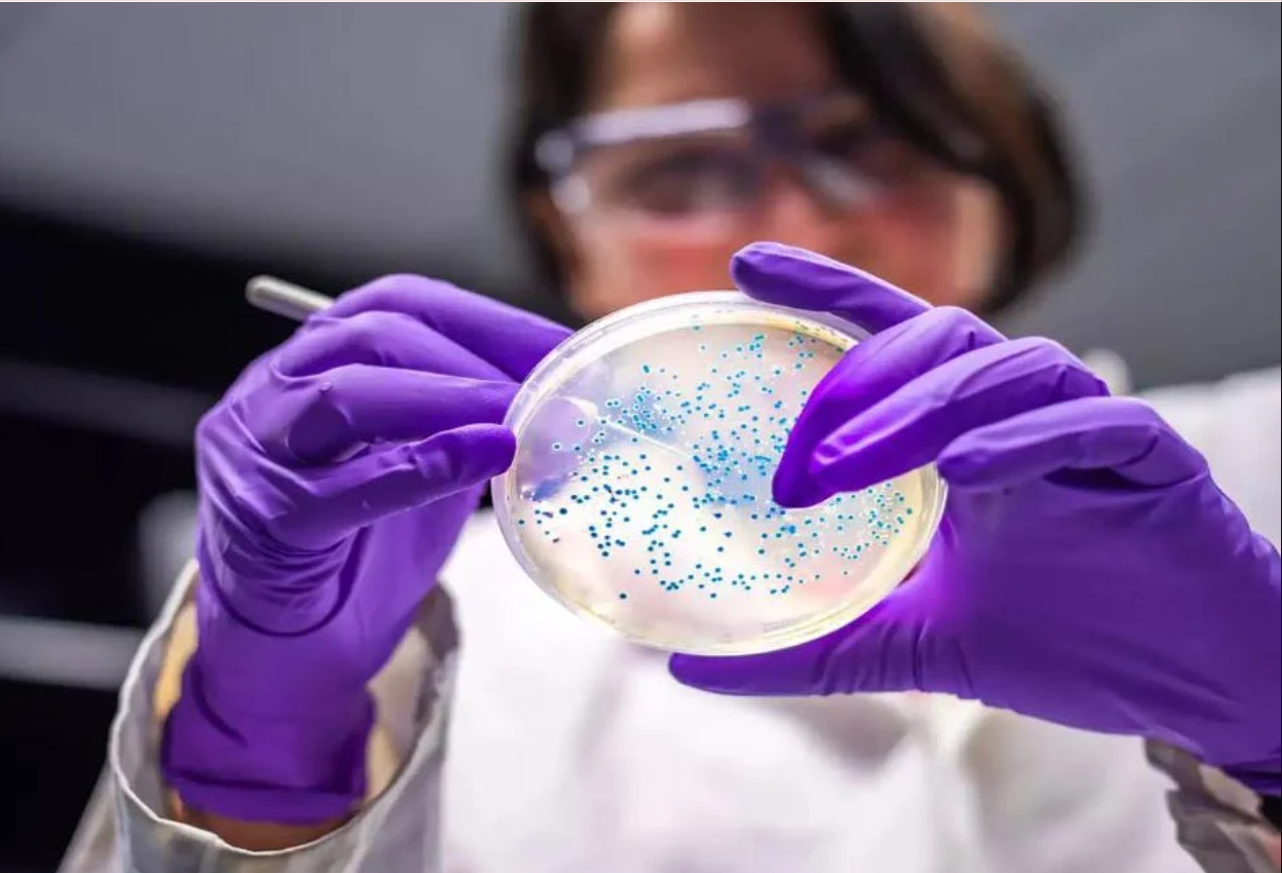

প্লাস্টিক দূষণ ঠেকাতে অভাবনীয় সাফল্যের দেখা পেয়েছেন জার্মানির একদল গবেষক। তাদের দাবি, ল্যাবের অব্যবহৃত পাইপ থেকে তারা তিন প্রজাতির ব্যাকটেরিয়ার বিশেষ এক দল খুঁজে পেয়েছেন, এরা একে অপরের সহযোগিতায় প্লাস্টিকের বিষাক্ত রাসায়নিক উপাদান বা ‘প্লাস্টিক অ্যাডিটিভ’ হজম করে ফেলতে পারে।
এনগ্যাজেট প্রতিবেদনে লিখেছে, দলবদ্ধভাবে কাজ করে কেবল ২৪ ঘণ্টায় ক্ষতিকর প্লাস্টিক বর্জ্য ধ্বংস করার এসব অণুজীব পরিবেশ রক্ষায় ব্যবহৃত হতে পারে। তবে এরা কেবল একসঙ্গে কাজ করেই এ অসাধ্য সাধন করতে পারে। গবেষণাটি প্রকাশ পেয়েছে বিজ্ঞানভিত্তিক জার্নাল ‘ফ্রন্টিয়ার্স ইন মাইক্রোবায়োলজি’তে।
তিনটি আলাদা প্রজাতির ব্যাকটেরিয়ার এ দলের মধ্যে রয়েছে দুটি ‘সিউডোমোনাস’ এবং একটি ‘মাইক্রোব্যাকটেরিয়াম’ প্রজাতির ব্যাকটেরিয়া। এসব ব্যাকটেরিয়া বেশ কিছু প্লাস্টিকের ‘থ্যালেট এস্টার’ ভেঙে ফেলতে পেরেছে। প্লাস্টিককে আরও নমনীয় বা ফ্লেক্সিবল করার জন্য সাধারণত এসব রাসায়নিক ব্যবহৃত হয়। প্লাস্টিক দূষণ বাড়ার সঙ্গে সঙ্গে এসব ক্ষতিকর রাসায়নিক ক্রমাগত পরিবেশে ছড়িয়ে পড়ছে। বিভিন্ন গবেষণা বলছে, এসব উপাদান মানুষের স্বাস্থ্য ও বন্যপ্রাণীদের জন্য ক্ষতিকর হতে পারে। গবেষক দলটি বাইরের কোথাও না গিয়ে নিজেদের ল্যাবেই পাওয়া যায় এমন অণুজীবের ওপর নজর দিয়েছিলেন।
তারা বায়োরিয়্যাক্টরের পলিইউরেথিন টিউবে তৈরি ‘বায়োফিল্ম’ আস্তরণ থেকে নমুনা সংগ্রহ করেছেন। এরপর সেই নমুনাটিকে এমন এক পরিবেশে রাখা হয়, যেখানে কার্বন ও শক্তির প্রধান উৎস হিসেবে ছিল ক্ষতিকর রাসায়নিক ‘ডিইপি’। গবেষণায় উঠে এসেছে, ৩০ ডিগ্রি সেলসিয়াস তাপমাত্রায় ব্যাকটেরিয়ার দলটি কেবল ২৪ ঘণ্টার মধ্যে সব ‘ডিইপি’ হজম করে ফেলেছে। তবে শর্ত হচ্ছে, প্রতি লিটারে এ রাসায়নিকের পরিমাণ ৮৮৮ মিলিগ্রামের বেশি হওয়া চলবে না।
‘ডিইপি’ ছাড়াও এ বিশেষ ব্যাকটেরিয়া দলটি আরও কয়েক ধরনের প্লাস্টিক রাসায়নিক, যেমন ডিএমপি, ডিপিপি ও ডিবিপি ধ্বংস করে বড় হতে পারে। গবেষকরা ডিএনএ সিকোয়েন্সিংয়ের মাধ্যমে এসব দলবদ্ধ ব্যাকটেরিয়াকে শনাক্ত করেছেন। তারা বলেছেন, এসব ব্যাকটেরিয়া আলাদাভাবে বা একা একা প্লাস্টিকের রাসায়নিক ধ্বংস করতে পারে না। এরা ‘ক্রস ফিডিং’ নামের এক সমবায় প্রক্রিয়ার মাধ্যমে একে অপরকে সাহায্য করে এ কঠিন কাজটি করে।
পরিবেশে প্লাস্টিক দূষণ ঠেকাতে এসব ব্যাকটেরিয়া শক্তিশালী হাতিয়ার হয়ে উঠতে পারে। এগুলো দূষিত এলাকা থেকে বিষাক্ত রাসায়নিক সরিয়ে ফেলতে বা প্লাস্টিককে ভঙ্গুর করে দিয়ে এর পচন প্রক্রিয়াকে বাড়াতে সাহায্য করবে। গবেষকরা বলেছেন, শিল্প-কারখানার প্লাস্টিক বর্জ্য শোধনের ক্ষেত্রেও এ পদ্ধতিটি কার্যকর হতে পারে।
তথ্য সূত্র- ফ্রন্টায়ার্স।